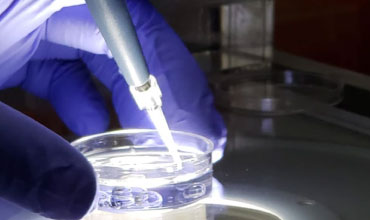

¿Necesita ayuda?
(+ 57 )318 280 0503

PIV Producción in Vitro
La producción in vitro (PIV) representa un avance revolucionario para el desarrollo de la industria ganadera tal como la conocemos hoy. Esta poderosa herramienta ha transformado los sistemas tradicionales de producción, permitiendo la implementación de genética seleccionada con un alto grado de precisión. A través de la producción de embriones bovinos in vitro, la ganadería latinoamericana ha experimentado un crecimiento exponencial, con mejoras sustanciales en la calidad y cantidad de animales producidos.
Pero, ¿cuáles son los beneficios concretos de este proceso? La PIV permite crear animales y realizar procedimientos personalizados, como la formación de núcleos de alta genética, ajustados específicamente a lo que el mercado o el cliente necesita. Esto resulta en un incremento directo de la productividad, ya que se optimizan los recursos genéticos disponibles para obtener animales de mayor valor y rendimiento.
Además, esta técnica permite lograr más crías de animales con características deseables en menos tiempo, favoreciendo un proceso de mejoramiento genético acelerado. Este tipo de reproducción asistida acorta los ciclos generacionales, lo que se traduce en un avance más rápido hacia una ganadería más eficiente y productiva.
Otro beneficio clave es la posibilidad de congelar embriones, lo que facilita la preservación del material genético incluso después de la muerte del animal, garantizando su disponibilidad para uso futuro. Esta capacidad de preservar la genética de alta calidad no solo asegura la continuidad de líneas genéticas excepcionales, sino que también facilita la comercialización de un gran número de embriones, brindando oportunidades para que los ganaderos amplíen sus operaciones de manera significativa.
Otro Beneficios

Optimización de recursos genéticos
La producción in vitro maximiza el uso de los recursos genéticos existentes, permitiendo una mayor eficiencia en la obtención de animales de alto rendimiento.
Aceleración del mejoramiento genético
Gracias a la capacidad de generar múltiples crías en menos tiempo, la PIV acelera el proceso de mejoramiento genético, lo que contribuye a una ganadería más competitiva.
Facilitación de la comercialización
La posibilidad de congelar embriones no solo asegura la preservación de la genética, sino que también abre oportunidades para la comercialización, permitiendo a los ganaderos expandir sus negocios.


